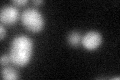

View description
Protein required for spore wall formation, thought to mediate assembly of a Don1p-containing structure at the leading edge of the prospore membrane via interaction with spindle pole body components; potentially phosphorylated by Cdc28p
Localization:
Intensity:
Fold change:
Significance:
-
C’ GFP library in SD

below threshold16.79 -
N' NOP1pr-GFP in SD

punctate54.9099 -
N' TEF2pr-mCherry in SD

punctate,nucleus35.665 -
N' NATIVEpr-GFP in SD

below threshold19.2083 -
N' TEF2pr-VC and Cyto-VN in SD

punctate30.8401 -
C’ GFP library in SD+DTT
cytosol18.171.08No -
C’ GFP library in SD+H2O2

cytosol150.89No -
C’ GFP library in Starvation Media

cytosol16.020.95No -
C’ GFP library on the background of Pup2-DaMP

below threshold -
C’ GFP library on the background of CCT mutant

below threshold16.05990.95577No
